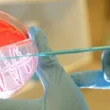

مقدمة عن فحص زراعة البول
يُعرف فحص زراعة البول طبيًا بمصطلح “زرع البول” باللغة الإنجليزية (Urine culture). يهدف هذا الفحص إلى التحقق من وجود جراثيم في عينة البول وتحديد عددها. يساعد هذا الإجراء في تأكيد أو استبعاد الإصابة بالتهابات الجهاز البولي، خاصةً لدى النساء، حيث أن النساء أكثر عرضة للإصابة بهذه الأنواع من الالتهابات مقارنة بالرجال.
عادة ما يتم إجراء هذا الفحص عند ظهور علامات أو أعراض قد تشير إلى وجود التهاب في المسالك البولية. تشمل هذه الأعراض:
- الحاجة الملحة والمتكررة للتبول.
- الشعور بالحرقة أثناء التبول.
- تغير لون البول وظهور رائحة كريهة.
- ألم في أسفل الظهر.
- الشعور بالضغط في منطقة أسفل البطن.
- وجود كمية صغيرة من الدم في البول.
- ألم في الجانب.
- ارتفاع درجة حرارة الجسم.
- الارتعاش.
- الشعور بالقشعريرة.
- الشعور بالغثيان أو التقيؤ.
كيفية إجراء فحص زراعة البول
يتم إجراء فحص زراعة البول عن طريق جمع عينة من بول الشخص المراد فحصه. يجب التأكد من غسل اليدين جيدًا قبل وبعد جمع العينة. من الضروري أيضًا تنظيف المنطقة المحيطة بفتحة البول باستخدام منديل معقم. بعد ذلك، يتم التبول في المرحاض لفترة قصيرة قبل إيقاف التبول مؤقتًا، ثم يتم جمع كمية من البول تتراوح بين 30 و 60 ملليلتر في الوعاء المخصص لجمع العينة. في بعض الحالات، قد يتم جمع عينة البول باستخدام قسطرة تحت إشراف متخصص الرعاية الصحية.
تفسير نتائج فحص زراعة البول
قد يختلف النطاق الطبيعي لنتائج فحص زراعة البول من مختبر إلى آخر. بشكل عام، تعني النتيجة الطبيعية لفحص زراعة البول “عدم وجود نمو”؛ مما يدل على عدم وجود عدوى في البول. أما النتيجة “الإيجابية” أو “غير الطبيعية” فتشير إلى وجود عدوى بكتيرية أو فطرية في البول، مما قد يشير إلى الإصابة بالتهاب المثانة أو التهاب المسالك البولية. في حال ظهور نتيجة إيجابية في فحص زراعة البول، قد يتم إجراء المزيد من الفحوصات لتحديد نوع الجراثيم أو الفطريات المسببة للعدوى واختيار المضادات الحيوية الأنسب للسيطرة عليها.